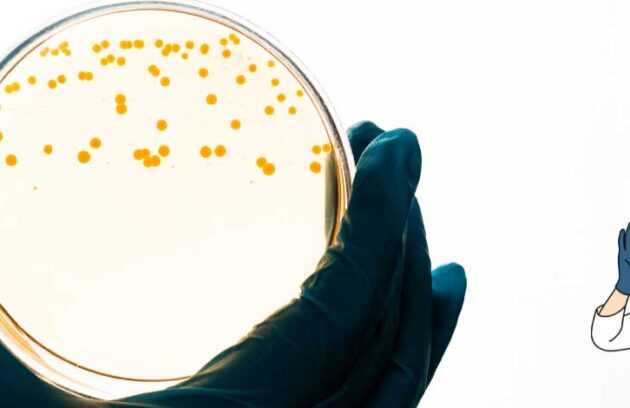

Uma nova descoberta no sistema imunológico feita por cientistas alimentam um novo rumo para antibióticos e para a medicina!
Pesquisadores fazem descoberta pertinente onde bactérias na boca podem indicar demência e maior risco à saúde cerebral
Partículas com microorganismos nocivos pelo ar representam um dos riscos de dar descarga com a tampa do vaso aberta. Saiba…
Veja como evitar germes e bactérias no colchão com dicas simples e eficazes para manter sua cama sempre limpa e…
Confira mais detalhes sobre a pesquisa que identificou quase 1 milhão de substâncias contra bactérias resistentes!
Entenda sobre a pesquisa que considerou bactérias e micro-organismos úteis para o diagnóstico do Câncer de Ovário.